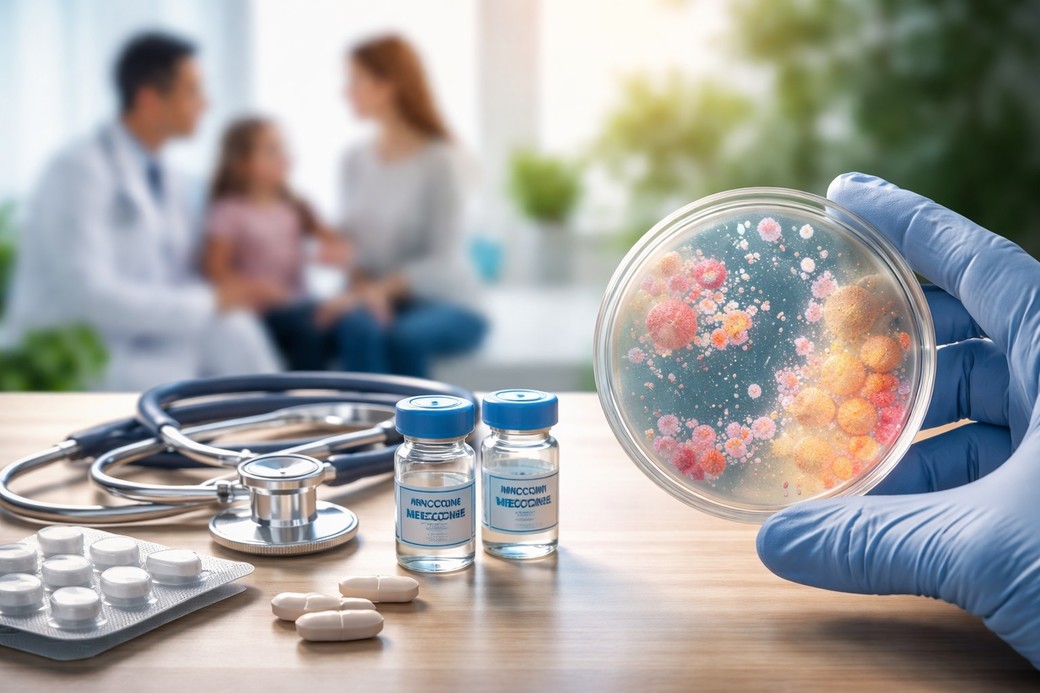
Risc foarte scăzut de răspândire în UE a focarului de boală meningococică din Marea Britanie, potrivit autorităţilor sanitare europene

Un focar recent de infecţie bacteriană severă, raportat în Marea Britanie, este considerat cu impact minim asupra populaţiei generale din Uniunea Europeană (UE). Autorităţile europene consideră că riscul de expunere şi îmbolnăvire este foarte redus, însă recomandă vigilenţă în identificarea cazurilor şi aplicarea rapidă a măsurilor de prevenţie în situaţii punctuale.
Centrul European de Prevenire şi Control al Bolilor (ECDC) a evaluat riscul asociat focarului de boală meningococică invazivă din Kent, Anglia, ca fiind foarte scăzut pentru populaţia din UE şi Spaţiul Economic European (UE/SEE).
Probabilitatea de expunere şi infectare este considerată neglijabilă.
Totuşi, „dacă este identificat un caz asociat focarului din Anglia în UE/SEE, trebuie iniţiate prompt măsuri de control pentru identificarea contacţilor apropiaţi şi administrarea profilaxiei antibiotice şi a vaccinului meningococic de tip B (MenB)”, a transmis ECDC într-un comunicat.
Potrivit Agenţiei pentru Securitate Sanitară din Regatul Unit (UKHSA), până la 18 martie au fost raportate 20 de cazuri de boală meningococică invazivă în Kent, dintre care două s-au soldat cu deces.
Focarele de meningită cauzate de bacteria Neisseria meningitidis apar, de regulă, în grupuri mici, în jurul cazurilor sau în locuri aglomerate. Deşi pot apărea cazuri secundare în rândul contacţilor apropiaţi, boala nu se răspândeşte în comunitate în acelaşi mod ca infecţiile respiratorii, precizează UKHSA.
Pentru persoanele expuse, care au fost vaccinate anterior împotriva meningococului de tip B, riscul de infecţie este redus, datorită protecţiei conferite de vaccin, precizează ECDC.
În cazul persoanelor nevaccinate care au fost expuse, riscul este considerat moderat.
După mai mult de zece zile de la expunere, probabilitatea de a dezvolta boala devine foarte scăzută, deoarece perioada de incubaţie este de maximum zece zile.
Medicii sunt sfătuiţi să ia în calcul diagnosticul de meningită la persoanele care se întorc din călătorii şi să includă istoricul de deplasare în evaluarea cazurilor suspecte, în special dacă au vizitat regiunea Kent.
„Lucrătorii din domeniul sănătăţii din ţările UE/SEE care gestionează cazuri suspecte sau confirmate trebuie să respecte protocoalele necesare de prevenţie şi control al infecţiilor, iar ţările sunt încurajate să continue supravegherea, inclusiv supravegherea moleculară şi testarea sensibilităţii la antibiotice, pentru a sprijini controlul focarului”, subliniază ECDC.
Boala meningococică invazivă este o infecţie bacteriană rară, dar severă, cauzată de Neisseria meningitidis, cu o rată ridicată de mortalitate.
Odată ajunsă în sânge, bacteria poate provoca meningită - inflamaţia membranelor care învelesc creierul şi măduva spinării -, sau septicemie, o formă gravă de infecţie a sângelui.
Evoluţia bolii este rapidă şi poate deveni fatală în absenţa tratamentului prompt cu antibiotice.
Incidenţa cea mai mare se înregistrează la copiii mici, adolescenţi şi adulţi tineri, iar sugarii sub un an sunt afectaţi disproporţionat.
În UE/SEE sunt raportate, în medie, aproximativ 2.000 de cazuri anual, dintre care circa 10% sunt fatale.
În 2023 au fost raportate 1.895 de cazuri şi 200 de decese, iar în 2024 numărul cazurilor a crescut la 2.263, cu 202 decese.
Serogrupul B a fost responsabil pentru 57% dintre cazuri în 2023 şi pentru 55% în 2024.
Programele de vaccinare din UE/SEE vizează în principal sugarii şi adolescenţii, folosind vaccinuri care protejează împotriva diferitelor serogrupuri ale bacteriei, inclusiv serogrupul B.
Vaccinarea poate fi recomandată şi altor grupe de vârstă, în funcţie de risc.
ECDC a mai anunţat că urmăreşte evoluţia focarului în colaborare cu autorităţile din Regatul Unit şi din statele UE/SEE, prin supraveghere epidemiologică combinată cu analiza genomică a bacteriei, şi va actualiza analiza situaţiei în funcţie de evoluţia focarului.